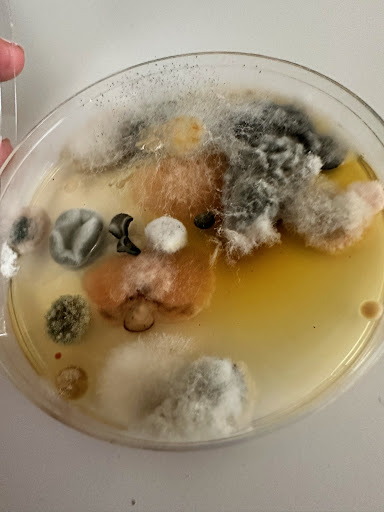

10X Las Olas Walk things to do, attractions, restaurants, events info and trip planning

Basic Info
10X Las Olas Walk
106 S Federal Hwy, Fort Lauderdale, FL 33301
4.2(227)
Open until 12:00 AM
Save
spot
spot
Ratings & Description
Info
Relaxation
Entertainment
Luxury
attractions: Riverwalk Fort Lauderdale, First Baptist Of Fort Lauderdale, Historic Stranahan House Museum, LauderGO! Water Trolley, Effusion Gallery | Las Olas, ABRA Gallery, Coastal Yacht Tours, Bellagio International Gallery, Chic Evolution in Art, Water Taxi Stop F2, restaurants: Café Bastille Fort Lauderdale, Sapido Italian Restaurant, Pizza , Wine , Market and Café, Bellagamba's Fine Italian Restaurant, The Wilder, Big City Tavern, Voodoo Bayou, El Camino Fort Lauderdale, IT! Italy Ristorante & Cafe & Bar, American Social - Bar & Kitchen - Fort Lauderdale, Lobster Bar Sea Grille, local businesses: Camden Las Olas Apartments, Dolce Medical Spa Las Olas | Facial | Skin Tightening | Microneedling, SeaTech Marine Electronics Services, Fort Lauderdale Airport Shuttle, Water Taxi Stop #F1, Bellas & Studz, Robinson's Jewelers, Carrie B Cruises, Yoga Joint Downtown Fort Lauderdale, Icon Las Olas Luxury Apartments
 Learn more insights from Wanderboat AI.
Learn more insights from Wanderboat AI.Phone
(954) 799-6490
Website
10xlasolaswalkapts.com
Open hoursSee all hours
MonOpen 24 hoursOpen
Plan your stay

Pet-friendly Hotels in Fort Lauderdale
Find a cozy hotel nearby and make it a full experience.

Affordable Hotels in Fort Lauderdale
Find a cozy hotel nearby and make it a full experience.

The Coolest Hotels You Haven't Heard Of (Yet)
Find a cozy hotel nearby and make it a full experience.

Trending Stays Worth the Hype in Fort Lauderdale
Find a cozy hotel nearby and make it a full experience.
Reviews
Live events

Rooted in Presence: Meditation & Kava Ceremony
Tue, Feb 24 • 8:00 PM
12009 Northwest 7th Avenue North Miami, FL 33168
View details

Plunge into the Arts with Deborah Perlman and Marie Altenburg
Fri, Feb 27 • 6:30 PM
4660 El Mar Drive Lauderdale-by-the-Sea, FL 33308
View details

MindTravel February Live-to-Headphones Piano Concert in Sunny Isles Beach
Sat, Feb 28 • 6:30 PM
16701 Collins Avenue Sunny Isles Beach, FL 33160
View details
Nearby attractions of 10X Las Olas Walk
Riverwalk Fort Lauderdale
First Baptist Of Fort Lauderdale
Historic Stranahan House Museum
LauderGO! Water Trolley
Effusion Gallery | Las Olas
ABRA Gallery
Coastal Yacht Tours
Bellagio International Gallery
Chic Evolution in Art
Water Taxi Stop F2

Riverwalk Fort Lauderdale
4.6
(710)
Open 24 hours
Click for details

First Baptist Of Fort Lauderdale
4.6
(210)
Closed
Click for details

Historic Stranahan House Museum
4.6
(310)
Closed
Click for details

LauderGO! Water Trolley
4.4
(306)
Closed
Click for details
Nearby restaurants of 10X Las Olas Walk
Café Bastille Fort Lauderdale
Sapido Italian Restaurant, Pizza , Wine , Market and Café
Bellagamba's Fine Italian Restaurant
The Wilder
Big City Tavern
Voodoo Bayou
El Camino Fort Lauderdale
IT! Italy Ristorante & Cafe & Bar
American Social - Bar & Kitchen - Fort Lauderdale
Lobster Bar Sea Grille

Café Bastille Fort Lauderdale
4.9
(5.3K)
$$
Closed
Click for details

Sapido Italian Restaurant, Pizza , Wine , Market and Café
4.7
(375)
$$
Closed
Click for details

Bellagamba's Fine Italian Restaurant
4.8
(603)
$$
Closed
Click for details

The Wilder
4.5
(584)
$$$
Open until 12:00 AM
Click for details
Nearby local services of 10X Las Olas Walk
Camden Las Olas Apartments
Dolce Medical Spa Las Olas | Facial | Skin Tightening | Microneedling
SeaTech Marine Electronics Services
Fort Lauderdale Airport Shuttle
Water Taxi Stop #F1
Bellas & Studz
Robinson's Jewelers
Carrie B Cruises
Yoga Joint Downtown Fort Lauderdale
Icon Las Olas Luxury Apartments

Camden Las Olas Apartments
3.6
(268)
Click for details

Dolce Medical Spa Las Olas | Facial | Skin Tightening | Microneedling
4.9
(188)
Click for details

SeaTech Marine Electronics Services
5.0
(62)
Click for details

Fort Lauderdale Airport Shuttle
4.9
(324)
Click for details
The hit list

Plan your trip with Wanderboat
Welcome to Wanderboat AI, your AI search for local Eats and Fun, designed to help you explore your city and the world with ease.
Powered by Wanderboat AI trip planner.